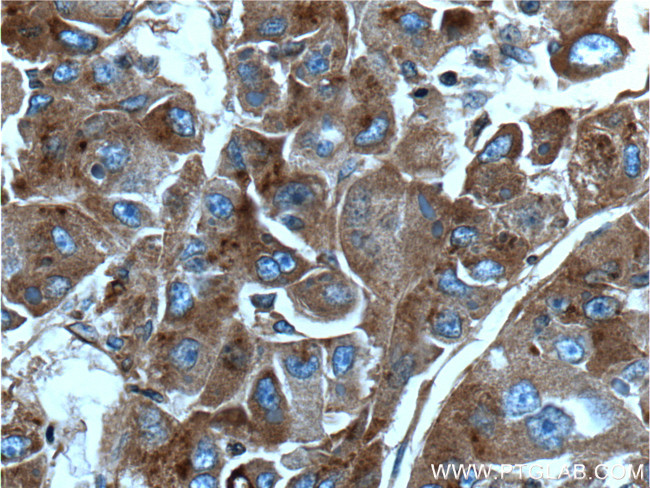
Apolipoprotein H Antibody in Immunohistochemistry (Paraffin) (IHC (P))
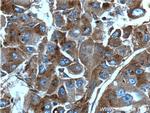
Apolipoprotein H Antibody in Immunohistochemistry (Paraffin) (IHC (P))
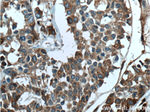
Apolipoprotein H Antibody in Immunohistochemistry (Paraffin) (IHC (P))
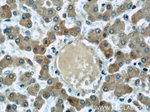
Apolipoprotein H Antibody in Immunohistochemistry (Paraffin) (IHC (P))

Search
Proteintech
Apolipoprotein H Monoclonal Antibody (4D9A4)
{{$productOrderCtrl.translations['antibody.pdp.commerceCard.promotion.promotions']}}
{{$productOrderCtrl.translations['antibody.pdp.commerceCard.promotion.viewpromo']}}
{{$productOrderCtrl.translations['antibody.pdp.commerceCard.promotion.promocode']}}: {{promo.promoCode}} {{promo.promoTitle}} {{promo.promoDescription}}. {{$productOrderCtrl.translations['antibody.pdp.commerceCard.promotion.learnmore']}}
产品信息
66074-1-IG
种属反应
已发表种属
宿主/亚型
分类
类型
克隆号
抗原
偶联物
形式
浓度
规格
纯化类型
保存液
内含物
保存条件
运输条件
产品详细信息
Immunogen sequence: GRTCPKPDD LPFSTVVPLK TFYEPGEEIT YSCKPGYVSR GGMRKFICPL TGLWPINTLK CTPRVCPFAG ILENGAVRYT TFEYPNTISF SCNTGFYLNG ADSAKCTEEG KWSPELPVCA PIICPPPSIP TFATLRVYKP SAGNNSLYRD TAVFECLPQH AMFGNDTITC TTHGNWTKLP ECREVKCPFP SRPDNGFVNY PAKPTLYYKD KATFGCHDGY SLDGPEEIEC TKLGNWSAMP SCKASCKVPV KKATVVYQGE RVKIQEKFKN GMLHGDKVSF FCKNKEKKCS YTEDAQCIDG TIEVPKCFKE HSSLAFWKTD ASDVKPC (20-345 aa encoded by BC026283)
靶标信息
Apolipoprotein H has been implicated in a variety of physiologic pathways including lipoprotein metabolism, coagulation, and the production of antiphospholipid autoantibodies. APOH may be a required cofactor for anionic phospholipid binding by the antiphospholipid autoantibodies found in sera of many patients with lupus and primary antiphospholipid syndrome, but it does not seem to be required for the reactivity of antiphospholipid autoantibodies associated with infections.
仅用于科研。不用于诊断过程。未经明确授权不得转售。
生物信息学
蛋白别名: 2GPI; Activated protein C-binding protein; Anticardiolipin cofactor; APC inhibitor; Apo-H; Apolipoprotein H; apolipoprotein H (beta-2-glycoprotein I); B2GPI; beta(2)GPI; Beta-2-glycoprotein 1; Beta-2-glycoprotein I; epididymis secretory sperm binding protein; unnamed protein product
基因别名: APOH; B2G1; B2GP1; B2GPI; beta-2-GPI; beta2-GPI; BG
UniProt ID: (Human) P02749, (Mouse) Q01339
Entrez Gene ID: (Human) 350, (Pig) 100522100, (Rat) 287774, (Mouse) 11818